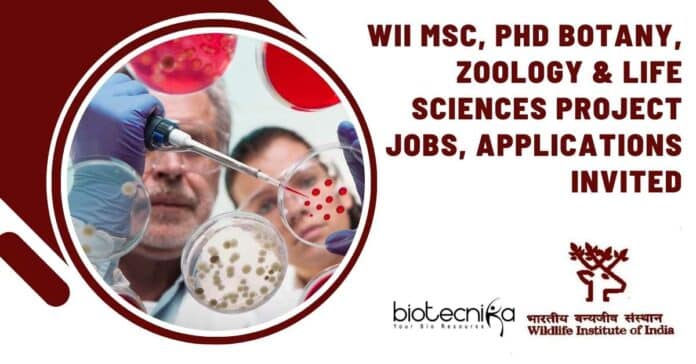

WII Research Positions Open For Life Sciences, Biotech, Biochem – Apply
WII Research Positions Open For Life Sciences, Biotech, Biochem – Apply. MSc Jobs. MSc Zoology. Botany and Life Sciences job openings. Interested and eligible applicants can check out all of the details on the same below
Hey there, are you looking for some assistance on possible interview questions and answers for the roles of Project Scientists & Associate Jobs at WII, then check out all of them below
This job expires in
(An Autonomous Institution of Ministry of Environment, Forest, and Climate Change, Government of India)
Chandrabani, Dehradun- 248001, India
EPBAX: 0135-2646112, FAX: 2640117
Website: www.wii.gov.in Email: [email protected]
Advt. No. ZSL/UKFD/WII/PM/3-2020
The Wildlife Institute of India (WII) is an internationally acclaimed Institution that offers a training program for government and non-government personnel, academic courses, and wildlife research and management advisory. The Institute is actively engaged in research across the breadth of the country on biodiversity-related issues.
WII, invites applications from INDIAN NATIONALS for 03 contractual positions of research personnel under the WII-UKFD-ZSL project of the Institute. This proposed project aims to contribute towards a viable tiger meta-population in the Terai Arc Landscape (TAL). It is part of the Integrated Tiger Habitat Conservation Programme (ITHCP) funded by the International Union for the Conservation of Nature (IUCN) and the German Development Bank, KfW. The area to be covered by the project extends over 1500 km squared, in Nandhaur Landscape. The main project components include management effectiveness, law enforcement, habitat management, and human-wildlife conflict (HWC), and livelihood development.
The period of contractual engagement, EQ, DQ, Age, Monthly Emoluments, and other details of the aforementioned positions are provided below:
Post I
Position Name: Project Scientist– II OR Project Scientist– I
No. of posts – 01
Name of the Project – Supporting trans-boundary tiger recovery in India and Nepal (Phase-III).
Upper Age Limit – 40
Duration – One (01) Year
Monthly Emoluments:
- For Project Scientist – II Rs. 67,000 + HRA
- For Project Scientist – I Rs. 56,000 + HRA
Essential Qualification (EQ): Doctoral Degree in Wildlife Science/Social Sciences/ Botany/ Zoology/ Forestry/ Life Science/ Agriculture/ Environmental Sciences from a recognized University.
AND
Three years experience in Research and Development in Industrial and Academic Institutions or Science and Technology Organisations and Scientific activities and services after Doctoral Degree
Desirable Qualification (DQ): Kannada-speaking candidate(s) will be preferred. Should be able to undertake arduous field work under dire conditions.
OR
Essential Qualification: Doctoral Degree in Wildlife Science/Social Sciences/ Botany/ Zoology/ Forestry/ Life Science/ Agriculture/ Environmental Sciences from a recognized University.
Description of Work –
- To establish participatory processes to identify access restrictions and mitigate (avoid, minimize, compensate) these impacts on the project site
- Prepare the HWC mitigation plan and livelihood intervention plan for the project villages
- Conduct Free, Prior and Informed Consent (FPIC) processes on project activities, beneficiaries and community of the project site
- Prepare a stakeholders engagement plan in consultation with affected groups and right holders
Post II
Position Name: Project Associate – II OR Project Associate – I
No. of posts – 01
Name of the Project –
- Community Livelihood & Human-Wildlife Conflict
- Camera Trapping and Patrol Based Monitoring
Upper Age Limit – 35
Duration – One (01) Year
Monthly Emoluments:
- For Project Associate – II Rs. 35,000 + HRA
- For Project Associate – I Rs. 31,000 + HRA
Essential Qualification (EQ): Master’s degree in wildlife science/ Botany/ Zoology/
Forestry/ Life Science/ Agriculture/ Environmental Sciences from a recognized University.
AND
Two years’ experience in Research and Development in Industrial and Academic Institutions or Science and Technology Organisations and Scientific activities and services after master’s Degree.
Desirable Qualification (DQ): Kannada-speaking candidate(s) will be preferred. Should be able to undertake arduous field work under dire conditions.
OR
Essential Qualification: Master’s degree in wildlife science/ Botany/ Zoology/ Forestry/ Life Science/ Agriculture/ Environmental Sciences from a recognized University.
Description of Work –
- Conduct a rapid socioeconomic survey in the project site and assess the level of human-wildlife conflict
- Design and conduct field surveys, data collection, and analysis and preparation of the report
- Experience of working on community mobilization, formation of groups and livelihood issues of local communities in the project site.
- Identify beneficiaries for different livelihood activities and mitigation measures
- Conduct focus group interviews and in consultation, with target local communities, facilitate training in a suite of feasible, economically viable livelihood opportunities for communities’ impact by the project and prepare technical reports.
- Conduct education and awareness program for increased awareness of wildlife among community members and educational institutions adjoining Nandhaur Landscape.
- Experience in community health and mainly women’s health
General Terms & Conditions
Mode of selection:
- Incomplete/late applications and applications not in the prescribed format are liable to be rejected.
- To apply for the above positions, candidates must send Hard Copy only of the filled application form (Annexure-I) and self-attested copies of certificates, documents, and testimonials by post/courier to Dr. Bilal Habib, Scientist-F, Dept. of Animal Ecology and Conservation Bilogy, Wildlife Institute of India, Chandrabani, Dehradun–248 001 (Uttarakhand), latest by by 1700hrs on Friday, 07th July 2023. The application should be superscipted with the title “Application for the position of _______________________ in the Project ______________________________ and Advertisement No. ZSL/UKFD/WII/PM/3-2020” on the envelope.
- Shortlisting of applications for an in-person interview will be based on essential qualification, age limit, NET/GATE qualification, percentage of marks in Bachelor and Master, specialization relevance in Masters, research experience (Publications, Paper Presented in Workshops/Seminars/Symposiums/Conferences), SOP and extracurricular activities (as per WII rules).
- Mere fulfilment of the minimum advertised qualification and experience requirement DOES NOT automatically entitle an applicant to be called for an interview. The decision of the Institute in all matters relating to eligibility, acceptance, or rejection of the application and mode of selection will be final and binding on the candidates. No inquiry or correspondence will be entertained from any individual or agency.
- A duly constituted Selection Committee will conduct all the recruitment process steps. However, if the Number of applications received for a particular post(s) is large, then Institute reserves the right to lay down any criteria to shortlist the candidates for interview
- All original documents/certificates must be produced at the time of joining for necessary verification.
- At the time of the verification of original documents or even after selection, if it is found that the applicant has attempted to wilfully conceal, misrepresent or canvass the facts, such applicant will not be considered for selection, and due action will be taken.
- Relaxation in the upper age limit shall be allowed in accordance with the Government of India, Ministry of Personnel, Public Grievances and Pensions (Department of Personnel & Training) OM No. 15012/2/2010-Estt. (D)dated 27.03.2012, as amended from time to time. However, the categories of upper-age relaxations are as follows:
a. Scheduled Castes and Scheduled Tribes up to 5 years.
b. Other Backward Class (OBC) up to 3 years. - The positions advertised are purely temporary/ contractual for the project period only. They will stand abolished after the completion of the project.
- The Institute’s rules and regulations govern the project’s tenure.
- After announcing the results, the candidate should join the project immediately.
- The Director WII reserves the right to reject any candidature because of incomplete information provided by the candidate or for any other reason.
Download the application format here
Check the notification below
- Question: Can you explain your experience in research and development in industrial and academic institutions or science and technology organizations? Answer: I have three years of experience in research and development after completing my doctoral degree in Wildlife Science. During this time, I have worked on various projects focusing on biodiversity conservation, habitat management, and human-wildlife conflict. My experience includes conducting field surveys, data collection and analysis, and preparing technical reports. I have also been involved in community mobilization and forming groups to address livelihood issues of local communities.
- Question: How would you establish participatory processes to identify access restrictions and mitigate the impacts on the project site? Answer: To establish participatory processes, I would engage with local communities and stakeholders through consultations, meetings, and workshops. I would ensure their active involvement in decision-making processes, allowing them to voice their concerns and suggestions. By understanding their perspectives, I would work towards finding solutions that minimize the impacts on the project site while addressing their needs and aspirations.
- Question: Have you conducted Free, Prior and Informed Consent (FPIC) processes before? Can you explain the steps involved? Answer: Yes, I have conducted FPIC processes in previous projects. The steps involved include: a. Informing the community about the project, its goals, and potential impacts. b. Providing relevant information to the community in a clear and accessible manner. c. Engaging in a dialogue with the community to address their questions, concerns, and expectations. d. Seeking the community’s consent through a transparent decision-making process. e. Documenting the consent in writing, ensuring it is voluntary and based on a full understanding of the project.
- Question: How would you design and conduct a rapid socioeconomic survey in the project site to assess the level of human-wildlife conflict? Answer: Designing and conducting a rapid socioeconomic survey involves the following steps: a. Identifying key variables to assess the level of human-wildlife conflict, such as livelihood patterns, perceptions, and economic dependencies. b. Developing a survey questionnaire with both quantitative and qualitative components. c. Conducting interviews or administering the survey to a representative sample of households in the project site. d. Analyzing the collected data to identify trends, patterns, and correlations related to human-wildlife conflict. e. Presenting the findings in a comprehensive report, highlighting the socioeconomic factors influencing conflict and potential mitigation measures.
- Question: How would you approach community health and women’s health as part of the project? Answer: As part of the project, I would adopt a holistic approach to community health and women’s health. This would involve: a. Conducting needs assessments to identify health-related challenges and priorities within the project site. b. Collaborating with local health authorities and organizations to provide access to healthcare services, education, and awareness programs. c. Organizing workshops and training sessions on topics such as hygiene, nutrition, and reproductive health, specifically targeting women. d. Promoting community participation in health initiatives and empowering women to take an active role in healthcare decision-making. e. Monitoring and evaluating the impact of health interventions and adjusting strategies based on the evolving needs of the community.
Remember to tailor your answers based on your own experiences, skills, and knowledge relevant to the position. Good luck with your interview!
Editor’s Note: WII Research Positions Open For Life Sciences, Biotech, Biochem – Apply. WII Research Positions Open 2023. WII Research Positions Open. Please ensure that you are subscribed to the Biotecnika Times Newsletter and our YouTube channel to be notified of the latest industry news. Follow us on social media like Twitter, Telegram, Facebook